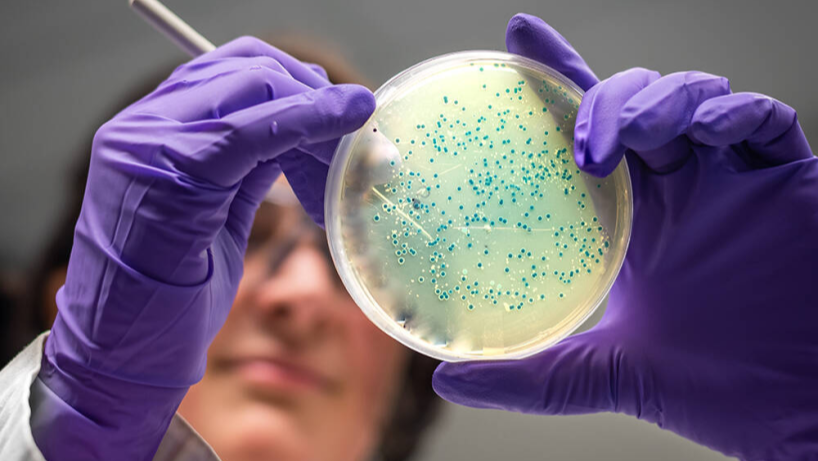

Сальмонеллёз — это одно из самых распространённых инфекционных заболеваний пищевого происхождения, вызываемое бактериями рода Salmonella. Эти микроорганизмы поражают желудочно-кишечный тракт, вызывая интоксикацию, обезвоживание и нарушения работы печени, желчного пузыря, поджелудочной железы и кишечника. Болезнь коварна тем, что часто начинается внезапно, может протекать в скрытой форме и приводить к серьёзным осложнениям, особенно при ослабленном иммунитете.
В медицинском центре «Альтернатива» лечение сальмонеллёза проводится комплексно, с акцентом не только на устранении инфекции, но и на восстановлении функций органов пищеварения, нормализации микрофлоры, детоксикации и коррекции патологических процессов.
Здесь используется озонотерапия, висцеральная терапия, лечебное голодание и диагностика на Комплексе Медицинском Экспертном (КМЕ) — инновационной системе, позволяющей определить глубину и источник патологического процесса.
Что представляет собой сальмонеллёз
Сальмонеллёз вызывается бактериями Salmonella enteritidis, Salmonella typhimurium и другими штаммами, устойчивыми к внешним условиям. В почве и воде они сохраняются до нескольких месяцев, а при заморозке — до года.
Попадая в организм человека, возбудитель быстро размножается в тонком кишечнике, выделяя токсины, которые нарушают обмен веществ, поражают сосуды и вызывают воспалительные реакции.
Основной источник заражения — животные и продукты животного происхождения: мясо, яйца, молочные продукты, особенно при нарушении правил хранения и приготовления.
Заражение также возможно через грязные руки, кухонные поверхности, посуду, воду, при контакте с инфицированными животными или людьми.
Причины заражения и факторы риска
К основным причинам сальмонеллёза относятся:
- Употребление заражённой пищи. Особенно часто заболевание возникает после употребления яиц с трещинами в скорлупе, недожаренного мяса или некипячёного молока.
- Контактно-бытовой путь. Через грязные руки, разделочные доски, кухонные приборы, игрушки и предметы гигиены.
- Недостаточная термическая обработка продуктов. Сальмонеллы выдерживают нагревание до 70 °C в течение нескольких минут, поэтому плохо прожаренные блюда представляют опасность.
- Снижение иммунитета. При хронических заболеваниях, стрессе, нарушениях питания организм менее устойчив к инфекциям.
- Нарушение кислотности желудочного сока. При пониженной кислотности создаются условия для выживания бактерий.
- Дисбактериоз и паразитарные инфекции. Они ослабляют барьерную функцию кишечника, способствуя проникновению сальмонелл.
Симптомы сальмонеллёза
Инкубационный период длится от 6 до 72 часов. Болезнь может проявляться в разных формах — от лёгкого пищевого отравления до тяжёлой генерализованной инфекции.
Типичные симптомы включают:
- резкую боль и спазмы в животе
- тошноту, рвоту, понос
- повышение температуры до 38–40 °C
- слабость, озноб, головную боль
- потерю аппетита, вздутие живота
- обезвоживание и падение артериального давления
В некоторых случаях развивается токсикоинфекционная форма, при которой бактерии проникают в кровь и поражают внутренние органы.
Это состояние требует немедленного медицинского вмешательства.
Возможные осложнения сальмонеллёза
Без своевременного лечения сальмонеллёз может привести к:
- поражению печени (токсический гепатит)
- воспалению желчного пузыря (холецистит)
- панкреатиту
- артритам и миокардиту
- нарушению работы почек и центральной нервной системы
Особенно опасно заболевание для детей, пожилых людей и пациентов с ослабленным иммунитетом.
Диагностика сальмонеллёза в МЦ «Альтернатива»
В медицинском центре «Альтернатива» диагностика сальмонеллёза проводится комплексно. Помимо традиционных лабораторных анализов (кровь, кал, моча), используется инновационная методика — Комплекс Медицинский Экспертный.
Что позволяет выявить КМЕ:
- бактериальную, вирусную и паразитарную нагрузку
- воспалительные процессы в желудочно-кишечном тракте
- нарушения функций печени, желчного пузыря и поджелудочной железы
- токсическую нагрузку на организм
- дефицит микроэлементов и ферментов
Диагностика на КМЕ даёт врачу возможность определить первопричину патологии, а не только последствия инфекции. Это особенно важно при хронических формах сальмонеллёза, когда бактерия сохраняется в кишечнике, вызывая периодические обострения.
Комплексное лечение сальмонеллёза в МЦ «Альтернатива»
Терапия в центре основана на принципах естественного восстановления организма. Цель — не просто уничтожить инфекцию, а восстановить внутренний баланс, микрофлору и нормальную работу всех органов пищеварения.
Методика восстановления всего организма при заражении сальмонеллёзом в МЦ «Альтернатива»
Проведение программы в условиях стационара на 5-10 суток или амбулаторного центра
- проживание в 1-но или 2-х местном номере / амбулаторно
- обследование: консультации врачей, УЗИ органов брюшной полости (печень, желчный пузырь, желчные протоки, поджелудочная железа, селезенка) и почек, ЭКГ, определение вирусов, бактерий, паразитов, дефицита витаминов и микроэлементов, пищевой непереносимости на Комплексе Медицинском Экспертном, лабораторные анализы
- гипоаллергенное питание: вегетарианское, сыроедение, сокотерапия
- лечебное голодание на 10-15 суток
- программа детоксикации: очищение толстого и тонкого кишечника, печени и желчного пузыря, почек, противопаразитарные, желчегонные, почечные чаи, массаж
- методы озонотерапии: внутривенное введение озонированного физраствора, проведение большой аутогемоозонотерапии, санация ЛОР-органов озоно-кислородной смесью, ректальные инсуффляции озоно-кислородной смесью, прием озонированной воды, прием озонированного масла, наружное применение озонированного масла, вагинальные инсуффляции озоно-кислородной смесью, обкалывание вокруг суставов (мышц вдоль позвоночника) озоно-кислородной смесью, санация уретры и мочевого пузыря озоно-кислородной смесью
- коррекция патологических процессов в организме на Комплексе Медицинском Экспертном: воздействие на паразитарную, грибковую, вирусную флору
- висцеральная терапия — массаж внутренних органов
- фотонная терапия
- аппаратный лимфодренажный массаж
Озонотерапия при лечении сальмонеллёза
Озоно-кислородная смесь обладает выраженным антибактериальным, противовирусным и иммуномодулирующим действием.
При сальмонеллёзе используется несколько форм озонотерапии:
- Внутривенное введение озонированного физиологического раствора при сальмонеллёзе применяется для быстрой дезинтоксикации организма при интоксикации, вызванной деятельностью сальмонелл. Раствор готовится непосредственно перед процедурой, насыщается озоном определённой концентрации и вводится капельно
- нейтрализует токсины, выделяемые бактериями
- активизирует работу печени и почек, ускоряя выведение продуктов распада
- улучшает тканевое дыхание и микроциркуляцию
- повышает энергетический обмен и устойчивость клеток к гипоксии
В результате снижается температура, нормализуется самочувствие и ускоряется восстановление после интоксикации.
- Большая аутогемоозонотерапия при сальмонеллёзе — метод заключается в заборе небольшого количества собственной крови пациента (обычно 100–150 мл), насыщении её озоно-кислородной смесью и последующем введении обратно в вену
- активирует иммунную систему, усиливая выработку антител к возбудителю сальмонеллёза
- оказывает выраженное антибактериальное и противовоспалительное действие
- улучшает текучесть крови и транспорт кислорода
- способствует регенерации слизистой кишечника и нормализации микрофлоры
Метод применяется в подострой стадии заболевания для ускоренного восстановления функций организма.
- Ректальные инсуффляции озоно-кислородной смесью при сальмонеллёзе особенно эффективны при кишечных инфекциях. Смесь подаётся в прямую кишку в контролируемом объёме и концентрации, воздействуя локально на слизистую кишечника.
- подавление патогенной флоры, включая сальмонеллу
- восстановление нормального микробиоценоза
- уменьшение воспаления и метеоризма
- ускорение регенерации слизистой кишечника
Благодаря мягкому локальному действию процедура переносится легко и помогает нормализовать стул и снять симптомы интоксикации.
- Санация ЛОР-органов озоно-кислородной смесью при сальмонеллёзе. У некоторых пациентов с сальмонеллёзом наблюдается вторичное воспаление слизистых оболочек (носоглотка, миндалины). Озонотерапия в виде местной санации используется для предупреждения бактериальных осложнений.
- уничтожает бактериальную и вирусную флору
- улучшает состояние слизистой, снимает отёк и воспаление
- ускоряет восстановление защитных функций верхних дыхательных путей
- Приём озонированной воды при сальмонелёзе. Озонированная вода обладает выраженным антисептическим и детоксикационным эффектом. Её применяют курсом для поддержки организма в период восстановления.
- снижает бактериальную нагрузку в желудочно-кишечном тракте
- стимулирует обмен веществ
- поддерживает водно-солевой баланс
- способствует мягкому очищению организма от токсинов
- Микроклизмы с озонированным маслом при сльмонеллёзе — оливковое озонированное масло вводятся в виде микроклизм в прямую кишку
- заживляют слизистую после воспалительных процессов
- восстанавливают эпителиальный слой кишечника
- предотвращают дисбактериоз
- оказывают противомикробное действие, не разрушая полезную флору
Такие процедуры применяются в завершающем этапе терапии для полного восстановления кишечной функции.
Комплексный эффект озонотерапии при сальмонеллёзе
Совмещение системных и местных методик обеспечивает многоплановое воздействие:
- устранение возбудителя и токсинов
- восстановление функций печени и кишечника
- укрепление иммунной системы
- ускорение регенерации тканей
- нормализация обменных процессов
Озоно-кислородная смесь уничтожает сальмонелл, усиливает выведение токсинов и активирует собственные защитные механизмы организма.
Детоксикация организма при сальмонеллёзе
После сальмонеллёза в организме накапливаются токсины, продукты распада бактерий и лекарственных средств.
Программа детоксикации в медицинском центре «Альтернатива» включает:
- очищение кишечника и печени
- поддержание водно-солевого баланса
- использование сорбентов и натуральных фитопрепаратов
- коррекцию питания и метаболизма
Детоксикация способствует снижению воспаления, восстановлению работы органов и устранению хронической усталости, которая часто остаётся после инфекции.
Висцеральная терапия при сальмонеллёзе
Висцеральная терапия — это мягкое ручное воздействие на внутренние органы через переднюю брюшную стенку.
При сальмонеллёзе она помогает:
- восстановить кровообращение в области печени, желчного пузыря и кишечника
- нормализовать моторику ЖКТ
- устранить застой желчи и отёк слизистых
- улучшить лимфоотток и процессы детоксикации
Метод безопасен, безболезнен и прекрасно сочетается с озонотерапией и диетологической коррекцией. Пациенты отмечают улучшение пищеварения, уменьшение вздутия и возвращение энергии уже после нескольких сеансов.
Лечебное голодание при лечении сальмонеллёза
Лечебное голодание при сальмонеллёзе используется как восстановительная и противовоспалительная методика.
Под контролем специалистов центра пациент проходит кратковременные периоды разгрузки, когда организм переключается на внутренние резервы.
Во время голодания:
- снижается уровень воспалительных цитокинов
- активируются процессы аутофагии (самоочищения клеток)
- нормализуется микрофлора кишечника
- ускоряется выведение токсинов
После курса лечебного голодания назначается индивидуальная программа питания, направленная на восстановление ферментативной активности и микробиома кишечника.
Восстановительный этап: питание и поддержка иммунитета
После острой фазы важно восстановить нормальное питание. Врачи центра подбирают персональную диету, включающую:
- лёгкие белковые блюда (отварное мясо, рыбу, кисломолочные продукты)
- овощные пюре, каши на воде
- пробиотики для восстановления микрофлоры
- ферментные препараты и витамины
Одновременно проводится иммуномодулирующая терапия и наблюдение на КМЕ, что позволяет оценивать динамику восстановления в реальном времени.
Профилактика сальмонеллёза
Чтобы избежать заражения, важно соблюдать простые правила:
- тщательно мыть руки и продукты питания
- хранить мясо и яйца отдельно от готовых блюд
- не употреблять сырые яйца, домашний майонез, непастеризованное молоко
- термически обрабатывать пищу не менее 10 минут при температуре выше 70 °C
- укреплять иммунитет с помощью полноценного питания и периодических программ очищения организма
Преимущества лечения сальмонеллёза в МЦ «Альтернатива»
- современный КМЕ-скрининг, выявляющий причину заболевания на глубинном уровне
- комплексное лечение без агрессивных антибиотиков — с опорой на озонотерапию, висцеральную коррекцию, лечебное голодание и детоксикацию
- индивидуальный подход и наблюдение врача до полного восстановления
- программы профилактики и поддержания здоровья пищеварительной системы
Врачи центра видят организм как единую систему, и потому лечение сальмонеллёза направлено не только на устранение инфекции, но и на восстановление баланса во всём теле.
Сальмонеллёз — заболевание, требующее внимательного отношения и комплексного подхода. Простое устранение симптомов не гарантирует полного выздоровления, если не устранена причина и не восстановлены функции органов пищеварения.
В медицинском центре «Альтернатива» лечение сальмонеллёза основано на принципах природного оздоровления, сочетая современные технологии (КМЕ, озонотерапия) и традиционные восстановительные методики (висцеральная терапия, лечебное голодание, детоксикация).
Такой подход помогает не только избавиться от инфекции, но и укрепить здоровье в целом, восстановив внутреннюю гармонию и жизненную энергию.